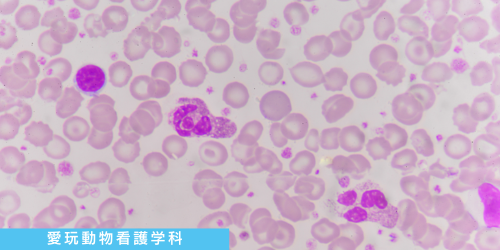

体験講座メニュー検索
- ←オススメ!興味のある学科と合わせてチェック!
-
202512/21Sun【高校2年生対象】2027年度入学説明会
進路決定の早期化が進む中、いよいよ具体的に進路を考える時期を迎える高校2年生の方に向けて、三者面談前に知っておきたい進路スケジュールや進学準備のポイントを分かりやすく説明します。説明会終了後に希望者は個別相談も可能。
参加特典:総合型選抜面接免除許可証・特待生試験の点数加点ほか
… -
202511/16Sun学生スタッフによる!ビジアカキャンパスツアー
学校を知りたいなら在校生に聞いてみよう!
授業のこと、休み時間の過ごし方、憩いスポットなど施設をマルっとご案内しながら楽しく紹介します。
開催時間 13:30~16:30 (受付13:00~) -
202511/16Sun経営学科まるわかり講座!
「経営ってどんなことを学ぶの?どんな仕事ができる?大学との違いは?」がなどがまるっと分かる!
開催時間 13:30~16:30 (受付13:00~) -
202511/16Sun宅建士合格の卒業生から秘密の攻略法を聞いちゃおう
宅建士に合格し、現在不動産業界で活躍している卒業生が、合格のための秘訣や攻略法を直接伝授!
勉強方法のコツを学べる絶好のチャンスです。この機会に、合格への一歩を踏み出しましょう。
開催時間 13:30~16:30 (受付13:00~) -
202511/16Sun学生起業も夢じゃない!「社長さんになるための話」
たくさんの社長さんから信頼されているコンサルタントのプロが社長になる秘訣を教えます。
開催時間 13:30~16:30(受付13:00~) -
202511/16Sun「企画職」を目指すなら絶対に知っておきたいマーケティングの話
ヒットする商品は、お客様や使う人の気持ちを考えることが大切です。大手企業でも使われている「売れる商品」の考え方を学ぼう!
開催時間 13:30~16:30(受付13:00~) -
202511/16SunオンラインもOK!オフィスビジネス学科まるわかり講座
「オフィスビジネス学科ってどんなことを学ぶの?どんな資格が取得できる?事務職に有利な資格は?就職サポートは?」がまるっと分かる内容です。
開催時間 13:30~16:30(受付13:00~) -
202511/16SunオンラインもOK!コミュニケーション上手になる心理学
心理ゲームを用いて楽しく授業!学校やビジネスシーンでもすぐに実践できるはず!
開催時間 13:30~16:30 (受付13:00~) -
202511/16Sun秘書のお仕事体験~お茶出し編~
正しいお茶の出し方を通して秘書のお仕事を体験してみよう
開催時間 13:30~16:30(受付13:00~) -
202511/16Sun「難しい」から「楽しい」にかわる! はじめてのデータ分析体験
AIを活用するために必要な「データ分析力」
データ分析ってどんなことをするの?が分かる入門講座です。
開催時間 13:30~16:30 (受付13:00~) -
202511/16Sunプロサッカーチームで働きたい人必見!サッカー業界で活躍する方法
なぜビジアカの卒業生はプロチームに就職できるのか?その秘密を全部教えます!
サッカーが好きなら絶対参加!
開催時間 13:30~16:30 (受付13:00~) -
202511/16Sun季節の花束を作ろう
色とりどりの季節のお花を使って、素敵な花束を作ってみよう!
開催時間 13:30~16:30 (受付13:00~) -
202511/16Sun大型犬トレーニング体験~コミュニケーション編~
トレーニングの基本的な動きやコミュニケーションの取り方を学ぼう!
開催時間 13:30~16:30 (受付13:00~) -
202511/16Sun【聴診器プレゼント♪】動物看護師の基本!健康チェック体験
現役の動物看護師が教える基本的な健康チェック。これであなたも動物看護師の卵!
本物の聴診器もプレゼント!
開催時間 13:30~16:30 (受付13:00~) -
202511/23Sun【高2生限定】年商10億!ムテキのコンビニをつくれ!~プロモーション編~
\進みたい分野を絞り込もう/
高2生限定★ドリームオープンキャンパス
バーチャルコンビニ出店ゲームで、売上がアップする「攻め」のプロモーションを楽しく体験!
進路特典として学費一部免除の特待生試験の点数加点ももらえます
開催時間 13:30~16:30(受付1… -
202511/23Sun【高2生限定】成功するビジネスの秘訣を探ろう!もしも、きみが有名企業の社員だったら?
\進みたい分野を絞り込もう/
★高2生限定★ドリームオープンキャンパス
有名企業が成功している理由を探り、自分のビジネスアイデアのブラッシュアップに役立てよう
進路特典として特待生試験の点数加点ももらえます。
開催時間 13:30~16:30(受付13:00~… -
202511/23Sun【高2生限定】自分に似合う色を診断してもらう!パーソナルカラー講座
\進みたい分野を絞り込もう/
高2生限定★ドリームオープンキャンパス
自分に似合う色を知ると洋服選びが変わる!美肌効果も!友達とのご参加も大歓迎♪
進路特典として学費一部免除の特待生試験の点数加点ももらえます
開催時間 13:30~16:30(受付13:00~… -
202511/23Sun【高2生限定】クイズで学ぼう!AI・IT検定
\進みたい分野を絞り込もう/
★高2生限定★ドリームオープンキャンパス
ビジアカでめざせるAI・IT系資格の内容を先取りしちゃおう!
進路特典として特待生試験の点数加点ももらえます。
開催時間 13:30~16:30(受付13:00~) -
202511/23Sun【高2生限定】世界を魅了するブランド戦略:NIKEのマーケティング戦略
\進みたい分野を絞り込もう/
高2生限定★ドリームオープンキャンパス
世界No.1ブランドの歴史と成功の秘訣やブランドの価値やその影響力からスポーツマーケティングの極意を伝授!
進路特典として特待生試験の点数加点ももらえます。
開催時間 13:30~16:30… -
202511/23Sun【高2生限定】オリジナルクリスマスリース制作
\進みたい分野を絞り込もう/
高2生限定★ドリームオープンキャンパス
オーナメント、リボンなどの素材を選んで、オリジナルクリスマスリースを作ろう
進路特典として学費一部免除の特待生試験の点数加点ももらえます
開催時間 13:30~16:30(受付13:00~) -
202511/23Sun【高2生限定】在校生から学校生活をいろいろ聞いてみよう
\進みたい分野を絞り込もう/
★高2生限定★ドリームオープンキャンパス
先輩からキャンパスライフや授業、バイトなど気になることを何でも聞いてみよう
進路特典として学費一部免除の特待生試験の点数加点ももらえます。
開催時間 13:30~16:30(受付13:00… -
202511/23Sun【高2生限定】ワンちゃんネコちゃんのホームケア~爪切り編~
\進みたい分野を絞り込もう/
高2生限定★ドリームオープンキャンパス
「血がでたらどうしよう」「大人しくしてくれない」そんなペットの爪切りの不安を解決!
進路特典として学費一部免除の特待生試験の点数加点ももらえます
開催時間 13:30~16:30(受付13:… -
202511/23Sun経営学科まるわかり講座!
「経営ってどんなことを学ぶの?どんな仕事ができる?大学との違いは?」がなどがまるっと分かる!
開催時間 13:30~16:30 (受付13:00~) -
202511/23Sunお金のプロになろう!講師と学生による「FP授業のリアル」を体験しよう
第一線で活躍しているファイナンシャルプランナー(FP)講師と現役学生の体験授業!
実際の授業で行っているお金に関するテーマでのディベートを体験しよう。先生と現役学生の授業を覗けるまたとないチャンス!
開催時間 13:30~16:30(受付13:00~) -
202511/23Sun【企画・販売・経営に興味がある方にオススメ】 新商品・新ビジネスを企画してみよう
商品企画は「どんな人に売るか」(ターゲット)で変わります。ターゲットの「こんなのあったらいいな!」を考えながら、商品企画を自由に楽しく学生と一緒に考えます。
開催時間 13:30~16:30(受付13:00~) -
202511/23Sun実践の中で課題解決力が身につく学科 ビジネスデザイン学科まるわかり講座
「ビジネスデザイン」って面白そうだけど何を学ぶの?「産学連携」「課題解決」「超実践授業」に興味のある方必見!
開催時間 13:30~16:30(受付13:00~) -
202511/23Sun\オンライン大歓迎/君のアイデアが日本を救う!「地域の課題発見×ビジネス」を教えます
「総合的な探求の時間」が好きな学生にオススメ!地域の問題をキミのアイデアで解決するノウハウをプロ講師が伝授します!
開催時間 13:30~16:30(受付13:00~) -
202511/23SunSNSマーケティングに興味のある方必見!「SNSを仕事に活用するテクニック」
Instagram・X・TikTokなどを活用したマーケティングに興味のある方はこちら!
開催時間 13:30~16:30(受付13:00~) -
202511/23SunオンラインもOK!オフィスビジネス学科まるわかり講座
「オフィスビジネス学科ってどんなことを学ぶの?どんな資格が取得できる?事務職に有利な資格は?就職サポートは?」がまるっと分かる内容です。
開催時間 13:30~16:30(受付13:00~) -
202511/23Sun就活や面接でも役立つビジネスマナー講座
就職活動や社会に出てから必要なビジネスマナーの基礎を丁寧に説明します!
開催時間 13:30~16:30(受付13:00~) -
202511/23Sun今注目の職業!データサイエンティスト徹底解剖
21世紀で最も注目される職業の一つ「データサイエンティスト」
どんな仕事をするのか、なるために何が必要なのかを分かりやすく解説します。
開催時間 13:30~16:30(受付13:00~) -
202511/23Sun「大好きなスポーツを仕事にする方法」スポーツをビジネスに変えよう!
スポーツがどうやってビジネスに繋がるのかを徹底解説!スポーツが好きで、それを仕事にしたいあなたにピッタリ!
開催時間 13:30~16:30(受付13:00~) -
202511/23Sunシーズナルイベントフラワーアレンジメント
もうすぐクリスマス!オリジナルクリスマスリースを制作してみよう
開催時間 13:30~16:30(受付13:00~) -
202511/23Sunトリマー気分!ワンちゃんのシャンプー体験
ワンちゃんのシャンプーを実際に体験してみよう!はじめての人でも大丈夫♪誰でもトリマー気分を体験できます
開催時間 13:30~16:30(受付13:00~) -
202511/23Sun【猫学】ネコから他の動物のことまで!幅広く生態を学ぼう
クイズ形式で学べる猫学!
今日からあなたもネコ博士!?猫以外の動物のことも学べます。
開催時間 13:30~16:30(受付13:00~) -
202511/30Sun経営学科まるわかり講座!
「経営ってどんなことを学ぶの?どんな仕事ができる?大学との違いは?」がなどがまるっと分かる!
開催時間 13:30~16:30 (受付13:00~) -
202511/30Sun実践!マーケティングリサーチ<街歩き型>コンビニおにぎりNo.1を探せ!
開催時間 13:30~16:30 (受付13:00~)
-
202511/30Sun身近に社長・個人事業主がいる方必見! 新たなビジネスを生み出すスキルを伝授!
新たな事業を考えたい、事業を継承&拡張したい方に向けて、今そのために必要なビジネススキルを教えます。
開催時間 13:30~16:30(受付13:00~) -
202511/30SunオンラインもOK!世界に通用する『マナー・プロトコールの基礎講座』
国際化が進む現代社会で、国際交流を踏まえたワンランク上のマナーを学ぼう!
開催時間 13:30~16:30 (受付13:00~) -
202511/30SunWEBプログラマー入門!HTMLでWEBデザイン体験
ホームページの画面デザインにはHTMLとCSSの知識が必要です。その仕組みを学んでWEBページを作ってみよう!
開催時間 13:30~16:30 (受付13:00~) -
202511/30Sunプロ直伝!スポーツトレーナーを目指すためには
スポーツトレーナーのプロからウエイトトレーニングや部活動でも活かせる栄養学を伝授します。
学内のスポーツジムで実際にトレーニングマシンを使った体験も!動きやすい服・室内履きをご持参ください。
開催時間 13:30~16:30(受付13:00~) -
202511/30Sunお部屋が華やかになる!フラワーインテリアを作ろう!
お部屋の雰囲気を明るくする艶やかなフラワーインテリア「ハーバリウム」作りにチャレンジしてみよう!
開催時間 13:30~16:30(受付13:00~) -
202511/30Sun大型犬トレーニング体験~アジリティ編~
ハードルや平均台を使用してワンちゃんと楽しくトレーニングをしよう!
開催時間 13:30~16:30(受付13:00~) -
202511/30Sunお口の健康を守ろう!動物の歯磨き体験
動物にとって全身の健康のポイントとなる「お口のケア」楽しく学びながら体験しよう!
開催時間 13:30~16:30(受付13:00~) -
202512/07Sun経営学科まるわかり講座!
「経営ってどんなことを学ぶの?どんな仕事ができる?大学との違いは?」がなどがまるっと分かる!
開催時間 13:30~16:30 (受付13:00~) -
202512/07Sunはじめてのビジネスアイデア~発想を形にしよう~
開催時間 13:30~16:30(受付13:00~)
-
202512/07Sun『企画力×実践!』SNSでバズる企画をつくるワークショップ
Instagram・X・TikTokなどを活用したマーケティングに興味のある方はこちら!
開催時間 13:30~16:30(受付13:00~) -
202512/07Sun<人気商品を作る方法>マーケティングの授業
人気商品はお客さまや使う人の気持ちを考えることが大切です。在校生から人気講師から「売れる商品」の考え方を学ぼう!
開催時間 13:30~16:30(受付13:00~) -
202512/07SunオンラインもOK!オフィスビジネス学科まるわかり講座
「オフィスビジネス学科ってどんなことを学ぶの?どんな資格が取得できる?事務職に有利な資格は?就職サポートは?」がまるっと分かる内容です。
開催時間 13:30~16:30(受付13:00~) -
202512/07Sun社会でも役立つ!パーソナルカラー診断
自分に似合う色を診断してもらおう!
開催時間 13:30~16:30(受付13:00~) -
202512/07Sunデータで未来を切り開く!データベース操作体験
実際の仕事で利用しているソフトのSQLを利用してデータを抽出してみよう!
開催時間 13:30~16:30(受付13:00~) -
202512/07Sunプログラミング言語トレンド1位!Python基礎講座
メジャーなプログラミング言語であるPythonを使って、プログラミングの初歩を勉強しよう
開催時間 13:30~16:30(受付13:00~) -
202512/07Sun\大学受験中でもOK/世界No.1スポーツメーカー「NIKE」のマーケティング術
世界中で愛されるNIKEの成功の秘密を大公開!スポーツ用品の開発やショップスタッフに興味がある人、見逃せないです!
開催時間 13:30~16:30 (受付13:00~) -
202512/07Sunお花屋さんはじめて講座
「フラワー業界のお仕事ってどんなものがある?どんな仕事をするの?」が分かるお仕事入門講座です。
開催時間 13:30~16:30(受付13:00~) -
202512/07Sun現役プロトリマーから学ぶ!ワンちゃんのカット体験
現役プロトリマーから学ぶカット技術!ハサミやコームの使い方などを体験しながら伝授します!
開催時間 13:30~16:30 (受付13:00~) -
202512/07Sun動物医療業界も注目!アニマルマッサージ教室!
今注目のアニマルリラクゼーション。ご家庭のワンちゃんネコちゃんにもできるマッサージ方法を体験!
開催時間 13:30~16:30 (受付13:00~) -
202512/13Sat経営学科まるわかり講座!
「経営ってどんなことを学ぶの?どんな仕事ができる?大学との違いは?」がなどがまるっと分かる!
開催時間 13:30~16:30 (受付13:00~) -
202512/13Sat学生起業も夢じゃない!「社長さんになるための話」
たくさんの社長さんから信頼されているコンサルタントのプロが社長になる秘訣を教えます。
開催時間 13:30~16:30(受付13:00~) -
202512/13Sat学科の強みが分かる60分!ビジネスデザイン学科が就職に有利な理由
迷ったらコレ!
卒業生全員が就職or起業を実現!企業やメディアも大注目のビジネスデザイン学科が就職に有利な秘密を大公開します。
開催時間 13:30~16:30(受付13:00~) -
202512/13Sat「フリマサイト」で学ぶ!「ブランド戦略」を知って「ビジネス」を学ぼう
ビジネス初心者にオススメ!写真撮影、商品説明、価格設定...フリマサイトへの出品で「ブランド戦略」の知識を学ぼう
開催時間 13:30~16:30(受付13:00~) -
202512/13Sat資産運用・投資入門ワーク:1000円から始めるマネーゲーム
授業でも行っている「投資シュミレーション」を使って、株・投資の模擬運用に挑戦しよう
開催時間 13:30~16:30(受付13:00~) -
202512/13SatオンラインもOK!オフィスビジネス学科まるわかり講座
「オフィスビジネス学科ってどんなことを学ぶの?どんな資格が取得できる?事務職に有利な資格は?就職サポートは?」がまるっと分かる内容です。
開催時間 13:30~16:30(受付13:00~) -
202512/13Satオリジナルメッセージカード作成♪Illustratorデザイン入門
イラストレーターソフトを使ってメッセージカードを作ろう
開催時間 13:30~16:30(受付13:00~) -
202512/13SatWEBプログラマー入門!HTMLでWEBデザイン体験
ホームページの画面デザインにはHTMLとCSSの知識が必要です。その仕組みを学んでWEBページを作ってみよう!
開催時間 13:30~16:30(受付13:00~) -
202512/13Satプロのサッカーチームで働きたい人必見!サッカー業界で活躍する方法
なぜビジアカの卒業生はプロサッカーチームに就職できるのか?その秘密を全部教えます!
サッカーが好きなら絶対参加!
開催時間 13:30~16:30(受付 13:00~) -
202512/13Sat憧れのウエディングブーケを作ってみよう
結婚式を華やかに彩るウエディングブーケを作ろう!将来のためのセンスアップに役立ちます。
開催時間 13:30~16:30 (受付13:00~) -
202512/13Sat大型犬トレーニング体験~コミュニケーション編~
トレーニングの基本的な動きやコミュニケーションの取り方を学ぼう!
開催時間 13:30~16:30 (受付13:00~) -
202512/13Sat獣医師先生と一緒に!医療機器を使って動物看護師体験
現役の獣医師の先生と一緒に動物看護師のお仕事体験!獣医さんと直接お話してみよう
開催時間 13:30~16:00(受付13:00~) -
202512/14Sun学生スタッフによる!ビジアカキャンパスツアー
学校を知りたいなら在校生に聞いてみよう!
授業のこと、休み時間の過ごし方、憩いスポットなど施設をマルっとご案内しながら楽しく紹介します。
開催時間 13:30~16:30 (受付13:00~) -
202512/14Sun経営学科まるわかり講座!
「経営ってどんなことを学ぶの?どんな仕事ができる?大学との違いは?」がなどがまるっと分かる!
開催時間 13:30~16:30 (受付13:00~) -
202512/14Sun売れる・人気を探るマーケティング
開催時間 13:30~16:30 (受付13:00~) -
202512/14Sun今、日本と海外をつなぐ「貿易」がアツい!「グローバルに活躍できる貿易講座」
今使っている文房具も、服も、スマホも・・・全て貿易に関係あるんです。
実はオモシロくて、世の中に欠かせない「貿易」の魅力について教えます!
開催時間 13:30~16:30(受付13:00~) -
202512/14Sun学科の強みが分かる60分!ビジネスデザイン学科が就職に有利な理由
迷ったらコレ!
卒業生全員が就職or起業を実現!企業やメディアも大注目のビジネスデザイン学科が就職に有利な秘密を大公開します。
開催時間 13:30~16:30(受付13:00~) -
202512/14Sun逆転発想!失敗した商品から成功の種を探してみよう
「売れると思ったのに、大失敗した商品」が世の中にはあります。失敗した原因を分析して、ビジネスをいつもと違う角度で見てみよう!
開催時間 13:30~16:30(受付13:00~) -
202512/14SunオンラインもOK!オフィスビジネス学科まるわかり講座
「オフィスビジネス学科ってどんなことを学ぶの?どんな資格が取得できる?事務職に有利な資格は?就職サポートは?」がまるっと分かる内容です。
開催時間 13:30~16:30(受付13:00~) -
202512/14Sun\参考書プレゼント/人気資格「秘書技能検定3級」プチ体験
秘書技能検定3級の授業体験。入学前に資格GETもめざせる!?参考書はそのままプレゼント!
開催時間 13:30~16:30(受付13:00~) -
202512/14SunオンラインもOK!コミュニケーション上手になる心理学
今の時代だからこそ「心理学」の授業は必須!心理ゲームを使って楽しく授業♪学校や職場でもすぐに実践できるはず!
開催時間 13:30~16:00(受付13:00~) -
202512/14Sun生成AIのしくみと使い方
生成AIについて、しくみの理解から始めて、どのようなことができるのかを分かりやすく解説します!
開催時間 13:30~16:30 (受付13:00~) -
202512/14Sunプロ直伝!【高3・社会人のための】スポーツトレーナー体験
スポーツトレーナーのプロからウエイトトレーニングや部活動・トレーニングでも活かせる栄養学を伝授します。
学内のスポーツジムで実際にトレーニングマシンを使った体験も!動きやすい服・室内履きをご持参ください。
開催時間 13:30~16:30(受付13:00~) -
202512/14Sunプレゼントでもらってうれしい♡フラワーボックスアレンジメント
人気講座★プレゼントでもらってうれしい、お洒落で可愛いフラワーボックスをアレンジメントしよう!
開催時間 13:30~16:30 (受付13:00~) -
202512/14Sunトリマー気分♥ワンちゃんのシャンプー体験
ワンちゃんのシャンプーを実際に体験してみよう!はじめての人でも大丈夫!誰でもトリマー気分が体験できます!
開催時間 13:30~16:30(受付13:00~) -
202512/14Sun【猫学】ネコから他の動物のことまで!幅広く生態を学ぼう
クイズ形式で楽しく学べる猫学!
今日からあなたも猫博士!?猫以外の動物のことも学べます。
開催時間 13:30~16:30 (受付13:00~) -
202512/20Sat経営学科まるわかり講座!
「経営ってどんなことを学ぶの?どんな仕事ができる?大学との違いは?」がなどがまるっと分かる!
開催時間 13:30~16:30 (受付13:00~) -
202512/20Sat在校生に聞く!「経営学科のキャンパスライフまるわかり講座」
勉強のことだけでなく、「どんな先生がいる?」「お昼ご飯は?」「アルバイトは?」など、リアルな学生生活を在校生に聞いてみよう!
開催時間 13:30~16:30 (受付13:00~) -
202512/20Sat学科の強みが分かる60分!ビジネスデザイン学科が就職に有利な理由
迷ったらコレ!
卒業生全員が就職or起業を実現!企業やメディアも大注目のビジネスデザイン学科が就職に有利な秘密を大公開します。
開催時間 13:30~16:30(受付13:00~) -
202512/20Sat『企画力×実践!』SNSでバズる企画をつくるワークショップ
Instagram・X・TikTokなどを活用したマーケティングに興味のある方はこちら!
開催時間 13:30~16:30(受付13:00~) -
202512/20Sat<人気商品を作る方法>マーケティングの授業
人気商品はお客さまや使う人の気持ちを考えることが大切です。在校生から大人気講師から「売れる商品」の考え方を学ぼう!
開催時間 13:30~16:30(受付13:00~) -
202512/20Sat「フリマサイト」で学ぶ!「ブランド戦略」を知って「ビジネス」を学ぼう
ビジネス初心者にオススメ!写真撮影、商品説明、価格設定...フリマサイトへの出品で「ブランド戦略」の知識を学ぼう
開催時間 13:30~16:30(受付13:00~) -
202512/20SatオンラインもOK!オフィスビジネス学科まるわかり講座
「オフィスビジネス学科ってどんなことを学ぶの?どんな資格が取得できる?事務職に有利な資格は?就職サポートは?」がまるっと分かる内容です。
開催時間 13:30~16:30(受付13:00~) -
202512/20Sat「難しい」から「楽しい」に変わる!はじめてのデータ分析体験
数学が苦手でもOK!AIを活用するために必要な「データ分析力」
データ分析ってどんなことをするの?が分かる入門講座です。
開催時間 13:30~16:30(受付13:00~) -
202512/20Sat2026年4月入学まだ間に合う!大好きなスポーツを仕事にする方法
スポーツがどうやってビジネスになるのかを徹底解説!スポーツが好きで、それをお仕事にしたいあなたにピッタリ!
開催時間 13:30~16:30 (受付13:00~) -
202512/20Sat季節の花束を作ろう!
色とりどりの季節のお花を使って、素敵な花束をつくってみよう!
開催時間 13:30~16:30 (受付13:00~) -
202512/20Sat大型犬トレーニング体験~アジリティ編~
ハードルや平均台を使用してワンちゃんと楽しくトレーニングをしよう
開催時間 13:30~16:30 (受付13:00~) -
202512/20Sat【聴診器プレゼント】動物看護師の基本!健康チェック体験
現役の動物看護師が教える基本的な健康チェック。これであなたも動物看護師の卵!本物の聴診器もプレゼント♪
開催時間 13:30~16:30(受付13:00~) -
202512/21Sun経営学科まるわかり講座!
「経営ってどんなことを学ぶの?どんな仕事ができる?大学との違いは?」がなどがまるっと分かる!
開催時間 13:30~16:30 (受付13:00~) -
202512/21Sun売れる・人気を探るマーケティング
開催時間 13:30~16:30 (受付13:00~) -
202512/21Sun学科の強みが分かる60分!ビジネスデザイン学科が就職に有利な理由
迷ったらコレ!
卒業生全員が就職or起業を実現!企業やメディアも大注目のビジネスデザイン学科が就職に有利な秘密を大公開します。
開催時間 13:30~16:30(受付13:00~) -
202512/21Sun君のアイデアが日本を救う!「地域の課題発見×ビジネス」を教えます
「総合的な探求の時間」が好きな学生にオススメ!地域の問題をキミのアイデアで解決するノウハウをプロ講師が伝授します!
開催時間 13:30~16:30(受付13:00~) -
202512/21SunオンラインもOK!オフィスビジネス学科まるわかり講座
「オフィスビジネス学科ってどんなことを学ぶの?どんな資格が取得できる?事務職に有利な資格は?就職サポートは?」がまるっと分かる内容です。
開催時間 13:30~16:30(受付13:00~) -
202512/21Sun就活や面接でも役立つビジネスマナー講座
就職活動や社会に出てから必要なビジネスマナーの基礎を丁寧に説明します!
開催時間 13:30~16:30(受付13:00~) -
202512/21Sunブラウザで動く「ドット絵RPGマップ開発」からプログラムを学ぼう
ゲーム開発のためのシンプルなオープンソースライブラリを利用して、RPGのマップ開発を体験!
既存のプログラムを修正して違うマップを描くので、初心者でも大丈夫。パズルのように頭を使う講座です。
開催時間 13:30~16:30 (受付13:00~) -
202512/21Sun\大学受験中でもOK/世界No.1スポーツメーカー「NIKE」のマーケティング術
世界中で愛されるNIKEの成功の秘密を大公開!スポーツ用品の開発やショップスタッフに興味がある人、見逃せないです!
開催時間 13:30~16:30 (受付13:00~) -
202412/21Satフローリスト入門♪はじめてのアレンジメント
フラワー体験初心者オススメの人気講座!キレイなアレンジメントを一緒に作ってみよう!
開催時間 13:30~16:30 (受付13:00~) -
202512/21Sun現役プロトリマーから学ぶ!ワンちゃんのカット体験
現役プロトリマーから学ぶカット技術!ハサミやコームの使い方などを体験しながら伝授します!
開催時間 13:30~16:30 (受付13:00~) -
202512/21Sunミクロの世界☆顕微鏡を使って血液の世界を覗いてみよう!
動物の身体に流れている血液を検査するのも動物看護師の重要なお仕事。
はたらく細胞を観察して探してみよう!
開催時間 13:30~16:00(受付13:00~) -
202601/11Sun経営学科まるわかり講座!
「経営ってどんなことを学ぶの?どんな仕事ができる?大学との違いは?」がなどがまるっと分かる!
開催時間 13:30~16:30 (受付13:00~) -
202601/11Sun学生起業も夢じゃない!「社長さんになるための話」
たくさんの社長さんから信頼されているコンサルタントのプロが社長になる秘訣を教えます。
開催時間 13:30~16:30(受付13:00~) -
202601/11Sun学科の強みが分かる60分!ビジネスデザイン学科が就職に有利な理由
迷ったらコレ!
卒業生全員が就職or起業を実現!企業やメディアも大注目のビジネスデザイン学科が就職に有利な秘密を大公開します。
開催時間 13:30~16:30(受付13:00~) -
202601/11Sun逆転発想!失敗した商品から成功の種を探してみよう
「売れると思ったのに、大失敗した商品」が世の中にはあります。失敗した原因を分析して、ビジネスをいつもと違う角度で見てみよう!
開催時間 13:30~16:30(受付13:00~) -
202601/11SunオンラインもOK!オフィスビジネス学科まるわかり講座
「オフィスビジネス学科ってどんなことを学ぶの?どんな資格が取得できる?事務職に有利な資格は?就職サポートは?」がまるっと分かる内容です。
開催時間 13:30~16:30(受付13:00~) -
202601/11SunオンラインもOK!世界に通用する「マナー・プロトコールの基礎講座」
「オフィスビジネス学科ってどんなことを学ぶの?どんな資格が取得できる?事務職に有利な資格は?就職サポートは?」がまるっと分かる内容です。
開催時間 13:30~16:30(受付13:00~) -
202601/11Sunプログラミング言語トレンド1位!Python基礎講座
メジャーなプログラミング言語であるPythonを使って、プログラミングの初歩を勉強しよう
開催時間 13:30~16:30 (受付13:00~) -
202601/11Sun\大学受験中でもOK/世界No.1スポーツメーカー「NIKE」のマーケティング術
世界中で愛されるNIKEの成功の秘密を大公開!スポーツ用品の開発やショップスタッフに興味がある人、見逃せないです!
開催時間 13:30~16:30 (受付13:00~) -
202601/11Sunお花屋さんはじめて講座
「フラワー業界のお仕事ってどんなものがある?どんな仕事をするの?」が分かるお仕事入門講座です。
開催時間 13:30~16:30(受付13:00~) -
202601/11Sunトリマー気分♥ワンちゃんのシャンプー体験
ワンちゃんのシャンプーを実際に体験してみよう!はじめての人でも大丈夫!誰でもトリマー気分が体験できます!
開催時間 13:30~16:30(受付13:00~) -
202601/11Sun国家資格【愛玩動物看護師試験】を模擬体験
愛玩動物看護師試験ってどんな問題が出るの?模擬問題をみてみよう!
開催時間 13:30~16:30 (受付13:00~)
来校者特典
予約者限定交通費サポート!
オープンキャンパスで来校された方の
交通費の一部を本校でサポートします。
- 対象者:
- 進路検討者ご本人(期間中は複数回ご利用可能です。)
- ご持参いただくもの:
- 学生証または身分証(現住所が確認できるもの、免許証・住基カードなど、公的書類でも可能です。)
| 東京23区内 | 500円 |
|---|---|
| 東京23区外 神奈川県・埼玉県・千葉県 |
1,000円 |
| 茨城県・栃木県・群馬県 | 2,000円 |
| 山梨県・長野県・静岡県 | 3,000円 |
| その他の地域 | 5,000円 |
総合型選抜(AO)エントリー資格進呈!
オープンキャンパスへのご参加で、総合型選抜(AO)エントリー資格を得られます。
AOプレスクールやAO特待生制度など、総合型選抜(AO入学)には特典がいっぱい!
ビジアカのオープンキャンパスに参加して総合型選抜(AO)エントリーしよう!
スケジュール
- 体験型オープンキャンパス
-
受付
13:00〜13:20興味のある学科は?進路活動のギモンや不安は?
あなたの知りたいことをビジアカの先生に教えてください。
事前に参加予約しているとスムーズです!学校説明
13:30〜14:05ビジアカってどんな学校?進学に向けてのスケジュールや入試・学費についてお話しします。学科説明
14:15〜14:50各学科の教室で、授業や資格・就職・サポート体制などについて説明します。体験講座
14:55〜15:40好きな講座を選んで体験!個別相談
15:45〜個別なので何でも気軽にお話しできます。
※相談内容によって時間が異なります。
- 学校説明会
-
受付
午前の場合:9:30〜
午後の場合:13:00〜興味のある学科は?進路活動のギモンや不安は?あなたの知りたいことをビジアカの先生に教えてください。
事前に参加予約しているとスムーズです!学校説明
約40分ビジアカってどんな学校?進学に向けてのスケジュールや入試・学費についてお話しします。
各学科の教室で、授業や資格・就職・サポート体制などについて説明します。個別相談
学校説明後個別なので何でも気軽にお話しできます。
※相談内容によって時間が異なります。
よくある質問
- オーキャンの前に先にいくつか質問をしたい
- オープンキャンパスって何回も行っていいの?
-
何回でも大丈夫です。ビジアカの在校生でも複数回来て検討した方が多いです。
- 持ち物、服装は?
-
必要なものは準備していますのでお持ちいただくものはありません。服装は私服の方が多いですが制服の方もいらっしゃいます。お好きな服装でお越しください。
- 1人でも参加できる?
-
お一人で参加される方も多くいらっしゃいます!先生と在校生がサポートしますので安心してお越しください。
- 授業見学はできますか?
-
事前に電話や公式LINEよりお問い合わせいただいた場合のみ、平日に授業見学・施設案内が可能です。急なご来校の場合、ご期待に沿えないことがございますのでご了承ください。
- 保護者や友人と一緒でも参加できる?
-
ぜひご一緒にご参加ください!保護者様も進路に関して気になる点はご相談いただくことが可能です。保護者様以外にも、お友達と一緒に参加される方も大歓迎です!